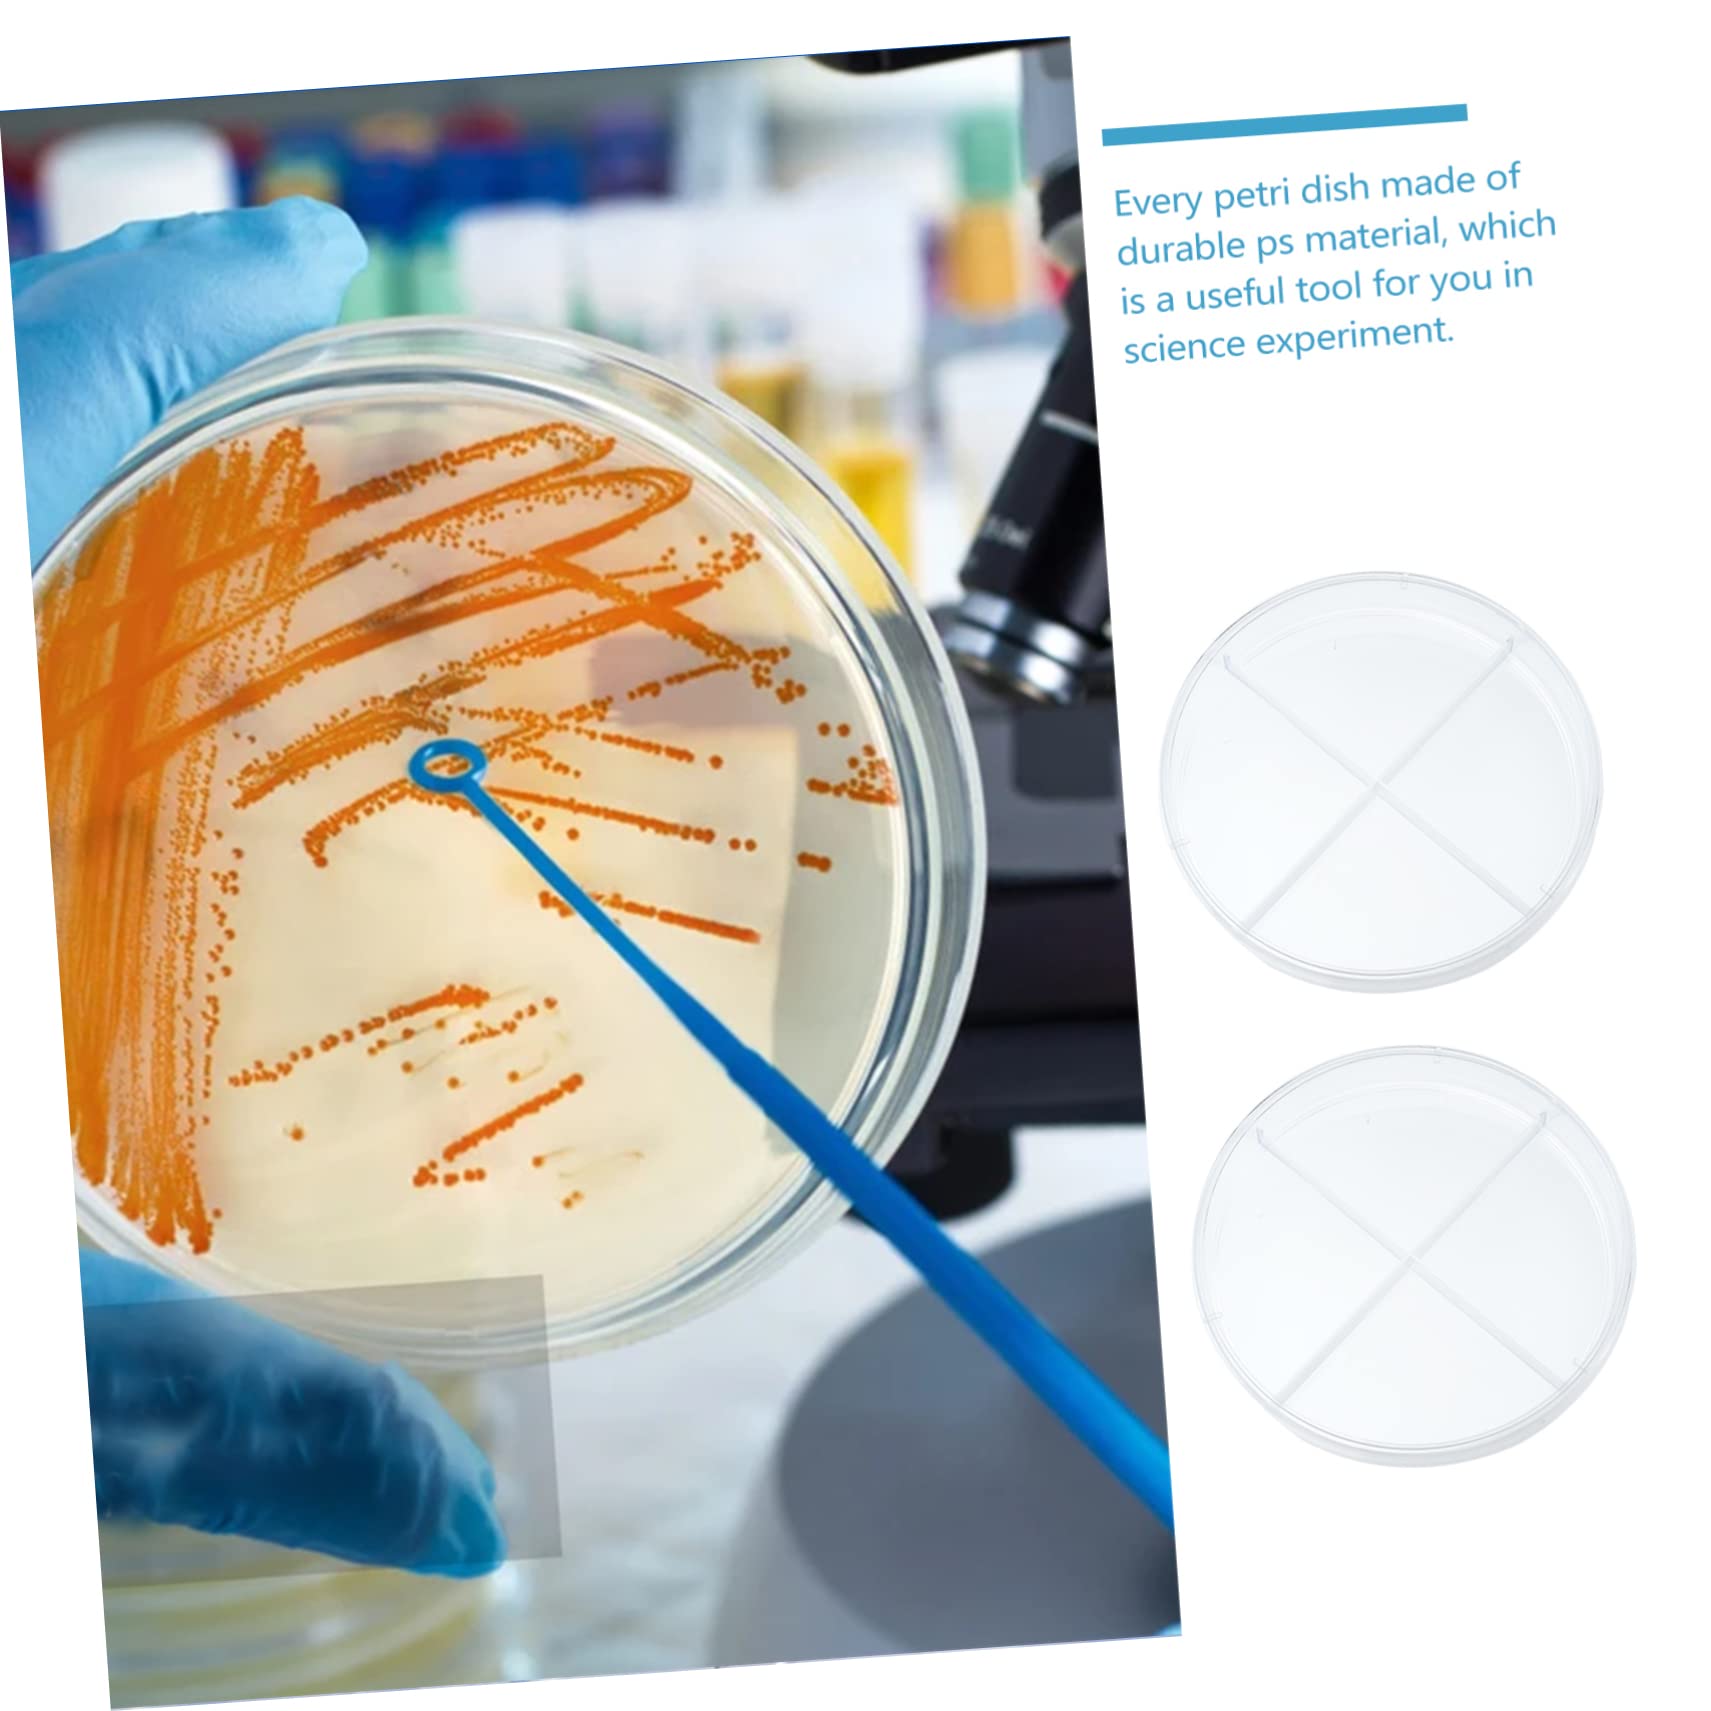
KICHOUSE Educational Teaching Aid 90mm Four Compartment Cell Culture Dish Set for Biology Lab

Product Information
Specification
AgeRangeDescription : big_kid
Brand : KICHOUSE
BulletPoint1 : Laboratory supplies-- the workmanship of this product is , and you will have a good experience in using it,lab tissue culture plate
BulletPoint2 : Transparent design petri dish-- suitable and for laboratory analysis, scientific research and other activities,scientific experiment supplies
BulletPoint3 : Clear petri dish-- easy to observe with transparent and clear look design, and the bottom of the flat and smooth,professional petri dish
BulletPoint4 : Experiment petri dish-- the transparent design is very convenient for you to observe under the microscope and explore the mysteries of science,four compartments petri dish
BulletPoint5 : Teaching aid-- four walled compartments design with beautiful appearance, easy to carry and use,plant supplies
Color : Transparent Color
CpsiaCautionaryStatement : no_warning_applicable
EducationalObjective : Creative Skills
IncludedComponents : storage holder
ItemDisplayDimensions_Length : 3.54 centimeters
ItemDisplayWeight : 0.29 pounds
ItemName : KICHOUSE Educational Teaching Aid 90mm Four Compartment Cell Culture Dish Set for Biology Lab
ItemPackageDimensions_Height : 4.72 inches
ItemPackageDimensions_Length : 5.91 inches
ItemPackageDimensions_Width : 4.72 inches
ItemTypeKeyword : science-lab-petri-dishes
ItemVolume : 1 cubic_centimeters
Manufacturer : KICHOUSE
ManufacturerMinimumAge : 180
Material : plastic
ModelName : Science Kits & Toys
ModelNumber : H717Y0087JXM8JJS
NumberOfBoxes : 1
NumberOfItems : 1
NumberOfLithiumMetalCells : 1
PartNumber : H717Y0087JXM8JJS
ProductDescription : Package List
10 x petri dishes
Features
-Size: About 900X900X150cm/354X354X059inch cell.
-Color: Transparent color molecular.
-Material: Plastic agar.
-Culture dishes is and uniform in thickness, but also light and thin compartment.
-It is suitable for cell observation experiments in schools, laboratories and other places round petri dishes.
-It is a very professional cell culture dish, which can make your scientific experiments Scientific Experiment Supplies.
-Small size, light weight, easy to use and carry, and will not take up too much space dishes.
-Four walled compartments design with beautiful appearance, easy to carry and use clear.
Goods Description
Portable Petri Dish These are cell culture dishes, made of high-class plastic materials, and , you can use them with confidence.lab cell culture plate Suitable for medicine, biology and scientific research.Scientific Experiment Tool The dishes have a flat growth surface for uniform cell growth without clumping and vents in the lid provide consistent gas exchange
ProductSiteLaunchDate : 2024-10-11T00:29:50.956Z
Size : 9x9cm
SupplierDeclaredDgHzRegulation : not_applicable
TargetAudienceKeyword1 : Unisex Adult
TargetAudienceKeyword2 : Unisex Adult
TargetAudienceKeyword3 : Unisex Adult
UnitCount : 1
UnspscCode : 41000000